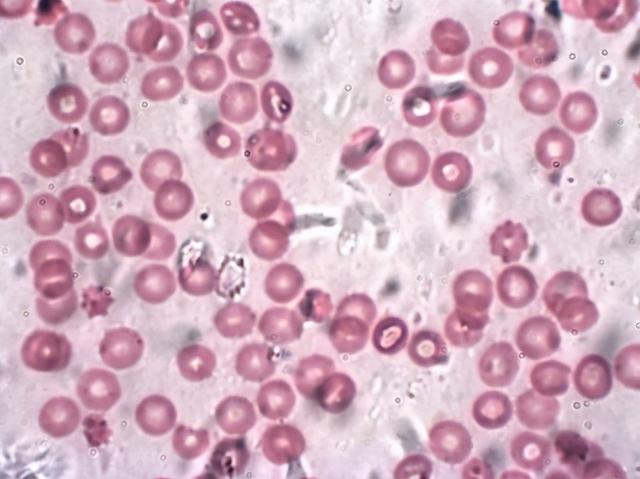

人的身體由約30兆個細胞構成。人體細胞每天都在不斷的死去,並生成新的細胞。科學家們表示,這種「細胞交替」規模比想像中的還要大。
據以色列Wizmann Institute of Science的生物學家Ron Sender和Ron Milo(Ron Milo)透露,人的身體每天會有約3300億個細胞重新生成並消失,相當於每秒鐘更換380萬個以上的新細胞。
其中大部分細胞是血液細胞,其次是腸道細胞。被替換的細胞不到2%是血液和腸道細胞以外的細胞。
研究小組表示:「確認一天生產的細胞數量有助於更好地了解人體的機能,以及細胞循環對健康和疾病的作用。」
科學家們到目前為止計算了體內有多少細胞,以及細胞壽命會達到多少,但是細胞的替換方面的研究幾乎沒有進行過。
在自然醫學(Nature Medicine)最新一期發表的論文中,研究小組調查了不同細胞類型出現的壽命變化,並用質量和數量來量化細胞的替換率。
研究小組在調查細胞數量時,以傳統的標準身體為基準。年齡20 ~ 30歲,體重70kg,身高170cm,認為健康標準的男性。
為了推算標準細胞替換率,研究小組調查了所有占身體整體細胞0.1%以上的細胞類型。
細胞壽命只調查了直接測量人體細胞壽命的資料。研究小組以平均細胞質量為基礎,根據各類型細胞導出了整個細胞質量。
以該信息為基礎,兩位科學家發現了標準人體每天更換的細胞數量為3300億個,按重量計算約為80g。
被替換的細胞86%是血液中的細胞,12%是胃腸細胞。少量的皮膚細胞(1.1%)、血管內的內皮細胞和肺細胞分別占0.1%。
血液細胞占據細胞交替的大部分,但從質量來看,血液細胞所占的比例只有48.6%。而細胞數量為12%的胃腸細胞所占的質量比例則為41%。皮膚細胞占4%,數量很少的脂肪細胞質量則占到了4%。
死亡細胞有時會脫落,或是寄生蟲吃掉或分解,部分則被再利用。當然,這個數據根據年齡、健康、身材、性別等因素的不同,每個人都會有所不同。
調查人體細胞交替時,還需要參考的是細菌的存在。生活在人身上的細菌由約38±10萬億個細胞組成,主要寄生在大腸中。這種細菌的總重量約為200g。
整體上,以體重70kg的標準人體為基準,人由30兆個細胞組成,整個細胞的重量為46kg。剩下的24kg是液體和固體物。
研究小組發現,人體每80天再生30萬億個細胞,每18個月產生46kg質量的細胞。
細胞替換率和細胞質量再生時間出現差異,是因為大部分細胞替換率發生在中小細胞中,而大質量的細胞則集中在平均壽命超過10年的細胞上。
但是,並不是人體所有的部分都會被替換。雖然細胞壽命也只有3 ~ 5天,但是構成整個細胞0.5%的腦神經細胞和眼睛晶體細胞一生都不會更換。因此,構成人體的所有細胞都不會發生完整的交替。